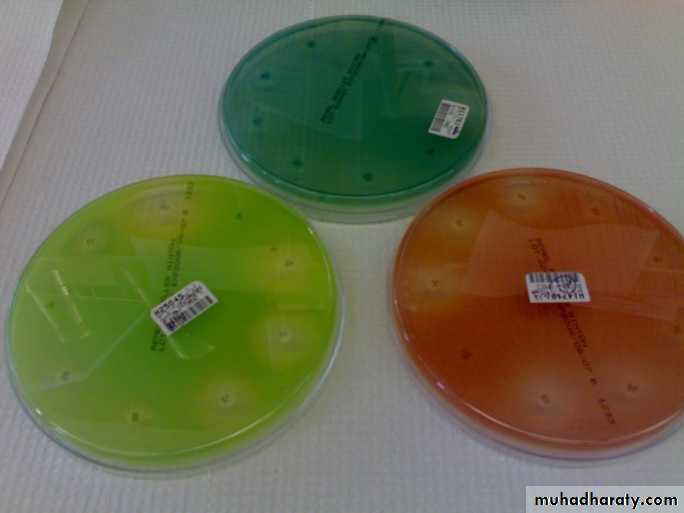
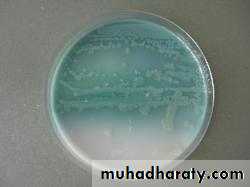

1
Practical microbiology Genus Pseudomonas
د.وليد خالد سعدون
2• Microscopical appearance
• Gram negative bacilli , slender and actively motile
• There are many species of Genus Pseudomonas , the most important species in human being is Pseudomonas aeroginosa
Cultural characters:-
-Obligatory aerobes that can grow on different culture media like nutrient agar, blood agar , chocolate agar and others. The growth can occur at a wide range of temperatures (6-42 C) with the optimum temperature of 37 C.-They form smooth, flat and large colonies with rounded or irregular edges with a fluorescent color, sweet odor, and B-hemolysis on blood agar.
4
The most distinguishing feature of Pseudomonas aeroginosa is the formation of diffusible pigmentation on nutrient agar .
There are 4 types of pigments produced :
1-Pyocyanin (bluish pigment) ; 2-Pyoverdin (greenish pigment);
3-pyorubin (reddish pigment ) ; 4-pyomelanin (black pigment)
5
Biochemical reactions
Catalase and oxidase tests are positive
Non fermentative for CHO
Glucose is utilized aerobically by oxidationIndole, MR ,VP and H2S tests are negative. Citrate utilization test is positive .
IMViC reaction is (-,-,-,+)
Oxidative fermentative test is O+ve/F-ve
6
Oxidative Fermentative (OF) test:-
-In this test we use two tubes of semisolid media that contain:
1- Low concentration of agar agar
2- High concentration of CHO
3- Bromothymol blue ( pH indicator which is normally green in color and becomes yellow in acidic pH) .
The two tubes are inoculated with the m.o. , then the first tube is covered with the mineral oil ( to prevent O2 from being in contact with the media) and the other tube is left opened.
7
8
-Then after 24-48 hours there will be oxidation of CHO in the opened tube ( as Pseudomonas aeroginosa is oxidative) changing the color of bromthymol blue from green to yellow, while the covered tube will remain green because the m.o. is not fermentative.
9
Also in this test the motility could be seen when the motile m.o. produce tree like appearance mainly toward the top of the tube ( aerobic m.o.)